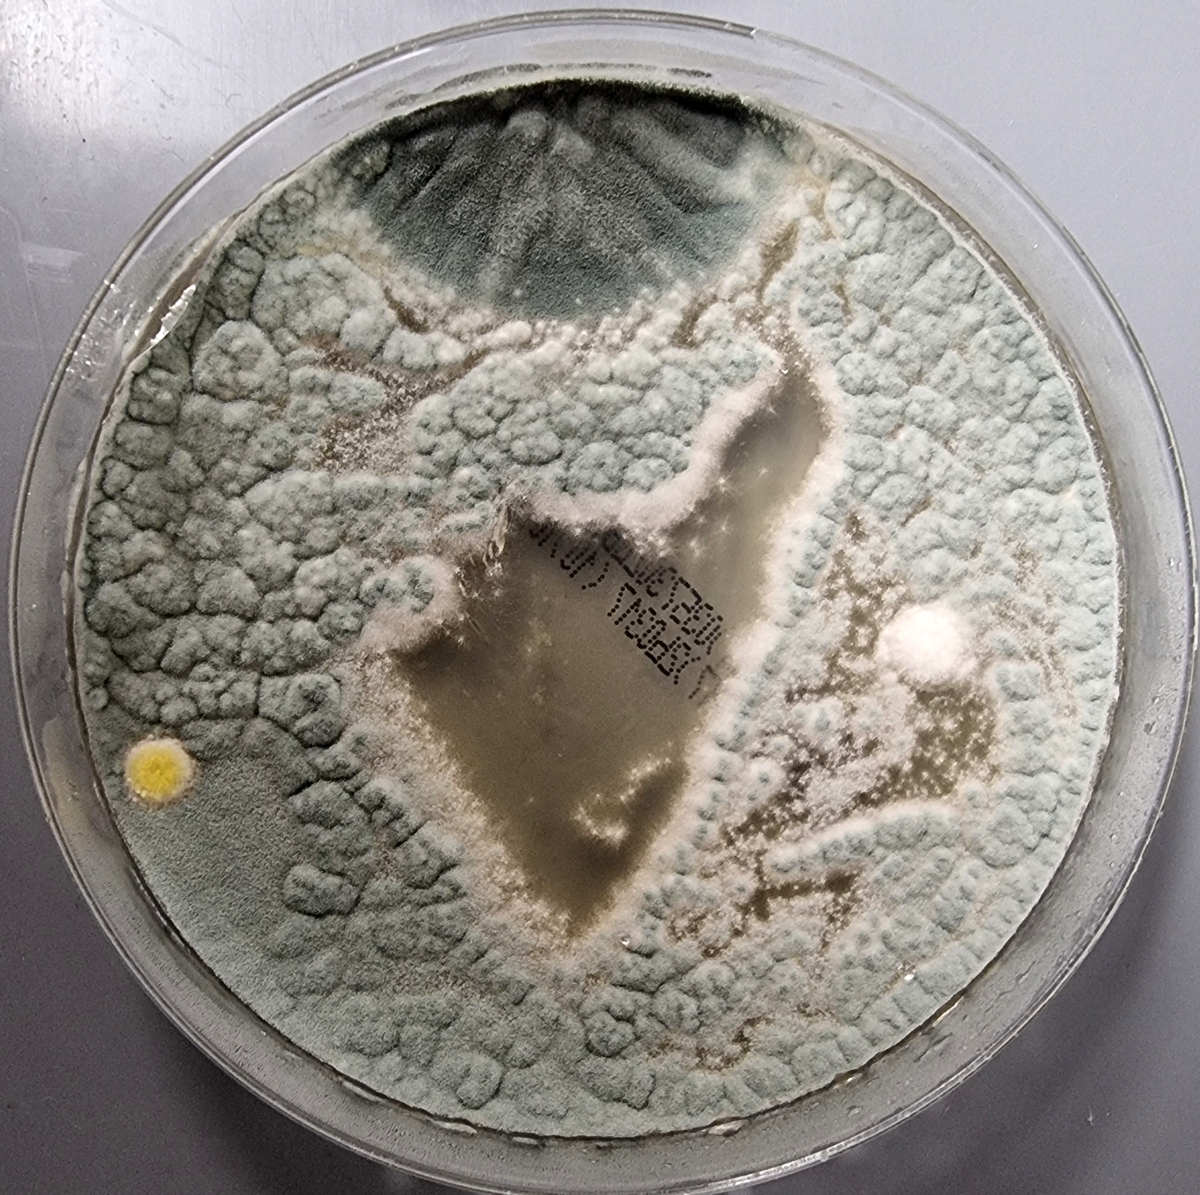

Schimmel in der Wohnung – erkennen, messen, verstehen
Schimmelpilze in Innenräumen sind weit verbreitet – oft unbemerkt. Nicht nur sichtbarer Schimmel an Wänden oder Fenstern ist relevant, sondern auch unsichtbare Sporen und deren Stoffwechselprodukte (Mykotoxine), die die Raumluft belasten und die Gesundheit beeinträchtigen können.
In der Seegarten Klinik bieten wir eine strukturierte Abklärung an, um sowohl die Wohnraum-Belastung als auch eine mögliche körperliche Belastung zuverlässig zu erfassen.
Warum kann Schimmel gesundheitlich relevant sein?
Schimmelpilze können flüchtige Sporen und Mykotoxine freisetzen. Je nach individueller Empfindlichkeit, Expositionsdauer und Gesamtbelastung können unter anderem auftreten:
- Chronische Müdigkeit, Erschöpfung
- Atemwegsbeschwerden, Husten, Druckgefühl auf der Brust
- Kopfschmerzen, Konzentrationsstörungen („Brain Fog“)
- Allergie-ähnliche Symptome
- Haut- und Schleimhautreizungen
- Verstärkung bestehender chronischer Erkrankungen
Nicht jeder reagiert gleich – deshalb ist eine objektive Messung entscheidend.
Unsere Diagnostik – zwei Ebenen
1. Messung der Raumluft mit Agarplatten
Mit speziellen Agarplatten lassen sich Schimmelsporen aus der Raumluft sichtbar machen. Diese Methode eignet sich als Screening, um Hinweise auf eine erhöhte Schimmelbelastung in Wohn- oder Arbeitsräumen zu erhalten.
Anwendung der Agarplatten (Anleitung)
- Mit wasserfester Marker Deckel anschreiben mit Name und Prüfort (Nicht auf dem Boden beschriften!) oder verwenden Sie Patienten-Etiketten, welche wir Ihnen mitgeben.
- Die Agarplatte am gewünschten Ort öffnen (z. B. Schlafzimmer, Wohnzimmer, Büro).
- Erst am Prüfort Deckel entfernen und neben der offenen Platte legen. Niemals Nährmedium berühren (Kontamination).
- 24 Stunden offen stehen lassen – nicht bewegen.
- Danach die Platte schliessen.
- Die geschlossene Platte luftdicht mit Cellophan umwickeln.
- Rückgabe an die Seegarten Klinik zur professionellen Bebrütung und Auswertung.
- Die Auswertung nimmt ca 3 Tage in Anspruch.
Die Agarplatte erlaubt keine exakte quantitative Raumluftanalyse, liefert jedoch wertvolle Hinweise, ob eine weiterführende Abklärung sinnvoll ist.
Eingewickelt in Cellophan

Negativer Befund

Positiver Befund
2. Mykotoxin-Panel im Blut
Ergänzend oder bei klinischem Verdacht messen wir im Blut ein Mykotoxin-Panel. Dabei werden spezifische Schimmelstoffwechselprodukte erfasst, die Hinweise auf eine tatsächliche körperliche Belastung geben können.
Diese Untersuchung ist besonders sinnvoll bei:
- Unklaren chronischen Beschwerden
- Verdacht auf längerfristige Exposition
- Diskrepanz zwischen Wohnraumsituation und Symptomen
Die Ergebnisse werden ärztlich interpretiert und immer im Gesamtkontext betrachtet.
Wie werden die Resultate beurteilt?
Die Befunde aus:
- Raumluft-Screening (Agarplatten)
- Mykotoxin-Analyse im Blut
- Klinik, Anamnese und Umweltfaktoren
werden zusammengeführt. Daraus ergeben sich individuell abgestimmte Empfehlungen, zum Beispiel:
- Weitere bauliche oder umweltmedizinische Abklärungen
- Reduktion der Exposition
- Unterstützung der körpereigenen Entgiftung
- Verlaufskontrollen
Unser Ansatz
Wir verfolgen keine pauschalen Aussagen, sondern eine differenzierte, medizinische Beurteilung. Nicht jeder Schimmelbefund bedeutet Krankheit – aber relevante Belastungen sollten ernst genommen und fachlich eingeordnet werden.
Interesse an einer Abklärung?
Gerne beraten wir Sie persönlich zur passenden Diagnostik und zum sinnvollen Vorgehen.